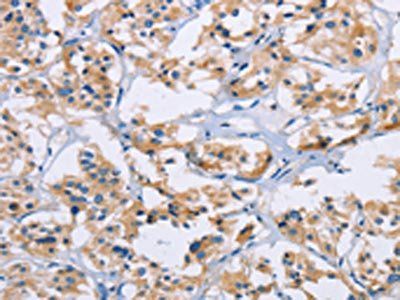
NCR3 Antibody
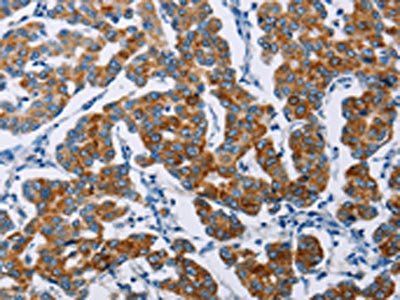
NCR3 Antibody

You have no items in your shopping cart.
Human NCR3 protein
Description
Research Area
Images & Validation
−
| Tested Applications | ELISA, MS, SDS-PAGE, WB |
|---|---|
| Application Notes |
Key Properties
−| Source | Human cells |
|---|---|
| Target | NCR3 |
| Reactivity | Human |
| Protein Sequence | LWVSQPPEIR TLEGSSAFLP CSFNASQGRL AIGSVTWFRD EVVPGKEVRN GTPEFRGRLA PLASSRFLHD HQAELHIRDV RGHDASIYVC RVEVLGLGVG TGNGTRLVVE KEHPQLGAGT VDDIEGRMDE PKSCDKTHTC PPCPAPELLG GPSVFLFPPK PKDTLMISRT PEVTCVVVDV SHEDPEVKFN WYVDGVEVHN AKTKPREEQY NSTYRVVSVL TVLHQDWLNG KEYKCKVSNK ALPAPIEKTI SKAKGQPREP QVYTLPPSRE EMTKNQVSLT CLVKGFYPSD IAVEWESNGQ PENNYKTTPP VLDSDGSFFL YSKLTVDKSR WQQGNVFSCS VMHEALHNHY TQKSLSLSPG K |
| Purity | Greater than 95% as determined by reducing SDS-PAGE. |
| Endotoxins | Less than 0.1 ng/μg (1 IEU/μg) as determined by LAL test. |
Storage & Handling
−| Storage | Lyophilized protein should be stored at -20°C, though stable at room temperature for 3 weeks. Reconstituted protein solution can be stored at 2-8°C for 2-7 days. Aliquots of reconstituted samples are stable at -20°C for 3 months. |
|---|---|
| Form/Appearance | Lyophilized |
| Buffer/Preservatives | 0.2 μM filtered solution of 20mM PB, 150mM NaCl, pH 7.4. |
| Expiration Date | 6 months from date of receipt. |
| Disclaimer | For research use only |
Alternative Names
−Similar Products
−Human NKp30 Protein, hFc Tag [orb689425]
Unconjugated
The purity of the protein is greater than 95% as determined by SDS-PAGE and Coomassie blue staining.
The protein has a predicted molecular mass of 39.0 kDa after removal of the signal peptide.The apparent molecular mass of NKp30-hFc is approximately 45-60 kDa due to glycosylation.
Mammalian
10 μg, 100 μg, 50 μgRecombinant Human NCR3 Protein [orb2994619]
Unconjugated
SDS-PAGE: Greater than 95% as determined by reducing SDS-PAGE.
Predicted: 40.2 KDa. Observed: 50-60 KDa, reducing conditions
1 mg, 10 μg, 50 μg, 500 μgRecombinant Human NCR3 Protein [orb2995113]
Unconjugated
SDS-PAGE: Greater than 95% as determined by reducing SDS-PAGE.
Predicted: 12.84 KDa. Observed: 19-33 KDa, reducing conditions
10 μg, 50 μg, 500 μg, 1 mg

Quality Guarantee
Explore bioreagents carefree to elevate your research. All our products are rigorously tested for performance. If a product does not perform as described on its datasheet, our scientific support team will provide expert troubleshooting, a prompt replacement, or a refund. For full details, please see our Terms & Conditions and Buying Guide. Contact us at support@biorbyt.com.
Documents Download
Request a Document
Protocol Information
Human NCR3 protein (orb392174)
Participating in our Biorbyt product reviews program enables you to support fellow scientists by sharing your firsthand experience with our products.
Login to Submit a Review